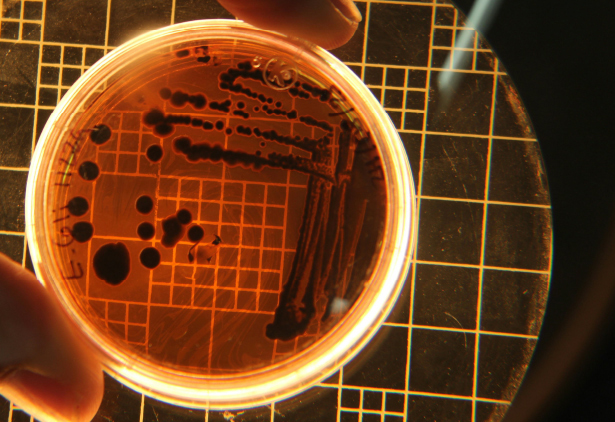
ILSA Group - Historical Timeline

Research
Research has played a crucial role for ILSA since 1976, when the first collaboration with the Faculty of Agriculture of the Università Cattolica del Sacro Cuore in Piacenza started, expanding over time to numerous national and international universities and research institutes.
Investing in research is a priority for ILSA because soil and plants are very complex biological systems that need to be investigated and understood with a multidisciplinary research approach.